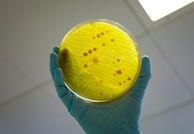

Antimicrobial Resistance
What is AMR?
Antimicrobial resistance (AMR) occurs when the pathogens that cause infection change to withstand the effects of treatments.
Read about what causes AMR and why it's such a serious threat to global health, resulting in millions of deaths per year.
Combating antimicrobial resistance through discovery science, technology development, policy, and precision medicine
Hundreds of Imperial College London researchers are working to understand and combat antimicrobial resistance (AMR). Below, learn how Imperial researchers across every Faculty and in dedicated Centres and Networks are funded and supported to:
- Uncover resistance mechanisms and pathogen biology
- Understand origins of AMR and track spread
- Develop cutting-edge technological, therapeutic, diagnostic, surveillance, policy, and decision-making solutions
Pick a topic to learn more about what we are doing
Infection and solutions
Explore Imperial's AMR research infrastructure and find an AMR expert
AMR news and events
Antimicrobial resistance news from Imperial College London researchers
Contacts
- Institute of Infection theme lead for AMR: Dr Andy Edwards
- For any other queries, contact Dr Melanie Bradnam (Manager, Institute of Infection)
- Sign up to receive emails and updates about AMR-related funding and activities